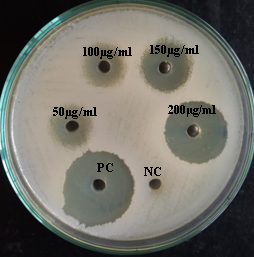

Int J Pharm Pharm Sci, Vol 11, Issue 3, 48-53Original Article
IN VITRO ANTIMICROBIAL ACTIVITY AND MIC OF THE EXTRACELLULAR ETHYL ACETATE CRUDE EXTRACT OF ENDOPHYTIC FUNGI FUSARIUM SP. ISOLATED FROM TEPHROSIA PURPUREA ROOT
DEEPENDRA THAKUR1, KAMANA SAHANI1,2*
1Department of Microbiology, Banglore University, Banglore, India, 2Department of Microbiology, Andhra University, Visakhapatnam, India
Email: kmnsahani@gmail.com
Received: 30 Jun 2018 Revised and Accepted: 22 Jan 2019
ABSTRACT
Objective: The objective of the present investigation was to find antimicrobial and MIC of endophytic fungi Fusarium sp. isolated from Tephrosia purpurea root.
Methods: Well diffusion assay was performed to find out the antimicrobial activity and Resazurin dye reduction method was performed to find out MIC of the extract.
Result: The extract showed the highest zone of inhibition of 22.66±0.57 mm, (Bacillus subtilis, MTCC-441) for Gram-positive bacteria and 20.66±0.57 mm, (E. coli, MTCC-443) for Gram-negative bacteria. Furthermore, the MIC of the extract was found to be (31.25 µg/ml-125 µg/ml).
Conclusion: Hence, the endophytic fungi isolated from the Tephrosia purpurea root, i.e. Fusarium sp. showed good antimicrobial activity and hence can be used to find a novel drug.
Keywords: Endophytes, Antimicrobial, MIC, Tephrosia purpurea root, Fusarium sp
© 2019 The Authors. Published by Innovare Academic Sciences Pvt Ltd. This is an open access article under the CC BY license (http://creativecommons.org/licenses/by/4.0/)
DOI: http://dx.doi.org/10.22159/ijpps.2019v11i3.28230
INTRODUCTION
There is a general call for new antibiotics, chemotherapeutic agents and agrochemicals that are highly effective possess low/no toxicity and will have a minor environmental impact. Worldwide, people are being threatened by dreaded disease accompanied with an increasing extent of environmental degradation, loss of biodiversity and spoilage of land and water caused by excessive toxic organic insecticide, industrial sewage and poisonous gases [1]. Thus, there is an urgent need to search chemically novel, natural, renewable and safe antimicrobial substances that can offer the opportunity for innovation of new drugs to combat against widespread pathogenic microbial infections [2]. Realizing the capability of microorganisms to produce a diverse bioactive molecule with serendipitous discovery of antibiotics penicillin from Penicillium notatum by Alexander Fleming sparked the beginning of “Golden age of antibiotics” [3], and the existence of unexplored microbial diversity.
Research is underway to isolate and screen microbes from diverse habitat and unique environment for discovery of novel metabolites. Fungi have been known to be a major source of active compounds used in medicine. One such unexplored and less studied microorganism is the endophytic fungi. Novel antibiotics, antimycotics, immunosuppressants, and anticancer compounds are only a few examples of what has been found after the isolation, culture, purification, and characterization of some choice endophytes in the recent past [2]. Plant-associated microorganisms, especially endophytic fungi, are largely unexplored in the discovery of natural products [4, 5].
A comparison of the different endophytic hosts which acquire a major proportion of biologically active isolates reveals that medicinal plants in a special environment and were frequently studied for screening antimicrobial endophytes up to date (fig. 1) [6]. This inspires many researchers across the world to highlight the antimicrobial activity of endophytic fungi associated with medicinal plants [7-11, 6]. The objective of the present study was to isolate endophytic fungi from Tephrosia purpurea, root and to check for their antimicrobial activity as well as MIC.

Fig. 1: Proportion of biologically active isolates from different sources tested for antimicrobial activities in recent researches [6]
MATERIALS AND METHODS
Collection of plant material
Visakhapatnam (Location 17 °40'48.32''N, 83 °12'5.8''E.) is situated between the Eastern Ghats and the Bay of Bengal. The annual mean temperature ranges between 24.7-30.6 °C (76-87 °F), with the maximum in the month of May and the minimum in January; the minimum temperatures range between 20-27 °C (68-81 °F) and the average annual rainfall recorded is 1,118.8 mm. The plant was located in the Campus of Andhra University. Healthy and mature plant of Tephrosia purpurea was collected from the Campus, Andhra University. Samples were tagged and placed in separate sterile polythene bags, brought to the laboratory and processed within 24 h of collection [12, 13]. Fresh plant material was used for the isolation work to reduce the chance of contamination. Sample collection was done in January 2016 and the plant used in the study was authenticated by Prof. S. B. Padal (Botanist), Department of Botany, Andhra University, Visakhapatnam and the plant material was also deposited in Botany Department herbarium (AUV), Andhra University, Visakhapatnam with Voucher specimen numbers–22295.
Isolation of endophytic fungi
The sample was washed thoroughly in running tap water before processing. Root samples were surface sterilized by dipping in 70% ethanol (v/v) for 1 min and 3.5% NaOCl (v/v) for 3 min, rinsed thrice with sterile water and dried. Bits of 1.0 X 1.0 cm size were excised with the help of a sterile blade. Two hundred segments of Tephrosia purpurea root segments were placed on the water agar (16%) (WA) medium supplemented with Streptomycin (100 mg/l; Sigma, St. Louis, MO, USA) were used for the isolation of endophytic fungi. The Petri dishes were sealed using parafilm and The Petri dishes were incubated at 25-27 °C till the mycelia start growing from the samples [14].
Test microorganisms
Test bacterial and fungal cultures were procured from Microbial Type Culture Collection (MTCC) of the Institute of Microbial Technology, Chandigarh. Cultures of Gram-negative bacteria, E. coli (MTCC-443), Klebsiella pneumoniae (MTCC-452), Proteus vulgaris (MTCC-426), Pseudomonas aeruginosa (MTCC-424), Sphingomonas paucimobilis (MTCC-6363) and Gram-positive Bacillus subtilis (MTCC-441), Bacillus Pumilus (MTCC-432), Streptococcus pyogenes (MTCC-2327), Staphylococcus aureus (MTCC-3160) were grown on Nutrient agar media and fungal species Aspergillus flavus (MTCC-3396), Aspergillus niger (MTCC-961), Candida albicans (MTCC-854) and were maintained on Potato dextrose agar which was further used for antimicrobial assay.
Preparation and standardization test microbial inocula for antimicrobial assay
Test microbial inocula for antimicrobial assay were prepared according to Clinical Laboratory Standards Institute [15]. For the growth method, a loop was used to touch the top of three to five colonies of the same morphological type from an agar plate culture. This was suspended in 10 ml of a sterile Nutrient broth (bacteria) (NB) and Potato Dextrose broth (yeast and filamentous fungi) (PDB) aseptically and incubated at 37 °C and 25 °C for bacteria and fungi respectively. The turbidity of the actively growing cells were adjusted to the 0.5 McFarland standard (at 625 nm, 0.08-0.1 absorbance in UV-VIS Spectrophotometer) using sterile respective broths to produce an standardized microbial inocula of approximately 1.5×108CFU/ml (for bacteria) and 0.5-2.5×103 yeast cells or spores/ml (yeasts and mold fungi) [16].
Primary Screening of endophytic fungal isolates
The isolated endophytic fungi were tested for preliminary antimicrobial activity by dual-culture agar diffusion assay [17], with some modifications. Petri dishes were prepared by pouring 20 ml of sterilized media (NA for bacteria and PDA for fungi) under the aseptic condition and allowed to solidify. After solidification of the media, 100 μl of standardized test microbial inocula of Gram-negative bacteria, E. coli (MTCC-443), Klebsiella pneumoniae (MTCC-452), Proteus vulgaris (MTCC-426), Pseudomonas aeruginosa (MTCC-424), Sphingomonas paucimobilis (MTCC-6363) and Gram-positive Bacillus subtilis (MTCC-441), Bacillus Pumilus (MTCC-432), Streptococcus pyogenes (MTCC-2327), Staphylococcus aureus (MTCC-3160) and fungal species Aspergillus flavus (MTCC-3396), Aspergillus niger (MTCC-961), Candida albicans (MTCC-854) (opportunistic pathogen) and were spread uniformly using sterile cotton swabs. Endophytic fungal isolates were grown at 25 °C-27 °C temperature for 7 d on antibiotic-free potato dextrose agar (PDA). 9 mm diameter of actively growing endophytic fungal agar blocks or discs were placed on the surface of the respective agar media seeded with test bacteria and fungi using sterile cork borer. Keeping at 4°C for 4 hr for the diffusion of antimicrobial metabolites, thereafter plates were incubated at 37°C for 24 hr and 25°C for 48 hr for bacteria and fungi respectively. The diameters of the inhibition zone around the discs were measured in millimeter (mm) and the average of three repeated agar discs was taken to assess the strength of antimicrobial activity.
Secondary metabolite production of endophytic fungal isolate
The endophytic fungus EF6 i.e. Fusarium sp.1 was cultured in 1-l Erlenmeyer flasks containing 500 ml of optimized culture media (PDB) under optimized parameters (pH: 5.5-6.5, Temperature: 25 °C-30 °C, Incubation days: 8-9 d) under static conditions. The culture broth was then filtered to separate the culture filtrate and mycelium. Culture filtrate was properly blended and centrifuged at 4,000 rpm for 5 min. The supernatant was transferred to a separating funnel to which was added the same volume of ethyl acetate. The funnel was strongly agitated and then the separation of the phases occurred by polarity differences. This process was repeated thrice. An ethyl acetate solution containing the fungal metabolite was 98% concentrated in a Büchi R-300 Rotavapor (India) at 50°C and stored at 4°C until its use [18].
Antimicrobial assay by well diffusion method
Well diffusion method was used to determine the antimicrobial activity of Endophytic fungal extract by the modifications of Clinical Laboratory Standards Institute [19-21] guidelines outlined by [22]. Petri dishes were prepared by pouring 20 ml of sterilized media (NA for bacteria and PDA for fungi) under the aseptic condition and allowed to solidify. After solidification of the media, 100 μl of standardized microbial inocula as per, Clinical Laboratory Standards Institute [13], was inoculated using sterile cotton swabs. Well was made using sterile cork borer (6 mm), 20 μl of endophytic fungal ethyl acetate extract at different concentration 200 μg/ml to 50 μg/ml for bacterial cultures and 300 μg/ml to 150 μg/ml for fungal cultures from the stock solution with the concentration of 1 mg/ml (For extracellular endophytic fungal extract) were inoculated. In other wells, supplements of DMSO and reference antimicrobial drug (Chloramphenicol) were used as negative and positive controls, respectively. The experiments were carried out in triplicate and plates were incubated at 37°C for 24 hr. After the incubation period, the diameters of zone of inhibition were measured around discs in mm as per Clinical Laboratory Standards Institute [23-24]. Each disk diffusion assay was performed in triplicates and mean diameters were recorded.
Resazurin based 96-well plate microdilution method
The MIC values of extracts were determined based on a micro-broth dilution method in 96 multi-well microtiter plates with slight modifications [25, 26]. A stock solution of resazurin sodium salt powder (Sigma Aldrich) was prepared at 0.02% (wt/vol) in distilled water and stored at 4 °C for up to 1 w.
A volume of 100 µl of test materials in 10% (v/v) DMSO (usually a stock concentration 1 mg/ml for crude extracts) added into the first row of the plate. 50 µl of nutrient broth and 50 µl of normal saline were added to each well of the plate. Serial dilutions were performed using a multichannel pipette such that each well had total l00 µl of the test material in serially descending concentrations. 10 µl of resazurin indicator solution was added in each well. Finally, 0.5 McFarland standard microbial suspension of l0 µl of bacterial and fungal suspension were added to each well to achieve a concentration of 1.5×108CFU/ml (for bacteria) and 0.5-2.5×103 yeast cells or spores/ml (yeasts and mold fungi) [16]. Each plate had a column with Chloramphenicol as the positive control and DMSO as the negative control for bacteria and Nystatin as the positive control and DMSO as the negative control in case of Fungi. The plates were prepared in triplicates and placed in an incubator set at 37 °C for 18-24 hr for bacteria and 25 °C for 48 hr for Fungi. Any color changes from purple to pink or to colorless indicated growth of microbes. The lowest concentration at which no color change occurred was taken as the MIC value of extract.

Fig. 2: Active living cells cause the reduction of resazurin (purple-blue) to resorufin (pink-colorless)
Statistical analysis
All statistical analysis was performed by using Microsoft Excel version 2013 and further mean±SD were calculated.
RESULTS
The secondary metabolites produced by the EF6, Fusarium sp.1 (fig. 3) isolated from the root of Tephrosia purpurea was used for the antimicrobial activity (antibacterial and antifungal activity). The extracellular, ethyl acetate extract was used for the antimicrobial activity (table 3, 4 and 6, fig. 4 and 6) and MIC (table 5 and 7 and fig. 5 and 7). The result of the preliminary antimicrobial activity is shown in table 1-2.

Fig. 3: Fusarium sp. 1 A: front view, B: Reverse view, C: microscopic image, D: cultivation at static condition for the production of secondary metabolites
Fig. 4: Antibacterial activity of EF6 i.e. Fusarium sp. 1 against E. coli (MTCC-443)
Table 1: Preliminary antibacterial activity
| Isolate No. | Preliminary antibacterial screening of endophytic fungi for antibacterial activity (mm) | ||||||||
| E. coli (MTCC-443) | Klebsiella pneumoniae (MTCC-452) | Proteus vulgaris MTCC-426) |
Pseudomonas aeruginosa (MTCC-424) |
Sphingomonas paucimobilis (MTCC-6363) | Bacillus subtilis (MTCC-441) | Bacillus pumilus (MTCC-432) | Streptococcus pyogenes (MTCC-2327) |
Staphylococcus aureus (MTCC-3160) |
|
EF6 (Fusarium sp.1) |
18.66 ± 0.57 |
12.66 ± 0.57 |
10.66 ± 0.57 |
13.66 ± 0.57 |
11.66 ± 0.57 |
19.66 ± 0.57 |
16.66 ± 0.57 |
17.66 ± 0.57 |
18.66 ± 0.57 |
Note: All the experiments were performed in triplicates and (Mean value±SD) were calculated
Table 2: Preliminary antifungal activity
| Isolate No. | Preliminary antifungal screening of endophytic fungi for antifungal activity (mm) | ||
| Aspergillus flavus (MTCC-3396) | Aspergillus niger (MTCC-961) | Candida albicans (MTCC-854) | |
| EF6 (Fusarium sp.1) | 11.66±0.57 | 10.66±0.57 | 14.66±0.57 |
Note: All the experiments were performed in triplicates and (Mean value±SD) were calculated
Table 3: Antibacterial activity of the extracellular endophytic fungal extract against Gram-negative bacteria
| Isolate No | The diameter of the zone of inhibition (mm) against pathogenic gram-negative bacteria at different concentration (µg/ml) | |||||||||||||||||||
E. coli (MTCC-443) |
Klebsiella pneumoniae (MTCC-452) | Proteus vulgaris (MTCC-426) |
Pseudomonas aeruginosa (MTCC-424) |
Sphingomonas paucimobilis (MTCC-6363) | ||||||||||||||||
| 200 | 150 | 100 | 50 | 200 | 150 | 100 | 50 | 200 | 150 | 100 | 50 | 200 | 150 | 100 | 50 | 200 | 150 | 100 | 50 | |
EF6 (Fusarium sp.1) |
20.66±0.57 | 14.66±0.57 | 10.66±0.57 | 6.83±0.28 | 14.6 6±0.57 | 10.6±0.57 | 7±0.5 | 00±00 | 12.66±0.57 | 9.66±0.57 | 00±00 | 00±00 | 15.6 6±0.57 | 11.66±0.57 | 8.66± 0.57 |
00±00 | 13.66±0.57 | 09.66±0.57 | 00±00 | 00 ± 00 |
| C20 | - | - | - | 23.66±0.57 | - | - | - | 20.66±0.57 | - | - | - | 18.66±0.57 | - | - | - | 19.66±0.57 | - | - | - | 21.66±0.57 |
Note: C20 represents Chloramphenicol at 20 µg/ml, the diameter of the well (6 mm) was included in ZOI value. All the experiments were performed in triplicates and (Mean value±SD) were calculated
Table 4: Antibacterial activity of the extracellular endophytic fungal extract against gram-positive bacteria
| Isolate No. | The diameter of the zone of inhibition (mm) against pathogenic Gram-positive bacteria at different concentration (µg/ml) | |||||||||||||||
Bacillus subtilis (MTCC-441) |
Bacillus pumilus (MTCC-432) |
Streptococcus pyogenes (MTCC-2327) | Staphylococcus aureus (MTCC-3160) | |||||||||||||
| 200 | 150 | 100 | 50 | 200 | 150 | 100 | 50 | 200 | 150 | 100 | 50 | 200 | 150 | 100 | 50 | |
EF6 (Fusarium sp.1) |
22.66±0.57 | 16.66±0.57 | 13.66±0.57 | 09.66±0.57 | 18.66±0.57 | 11.66±0.57 | 09±0.5 | 00±00 | 16.33±0.507 | 14.66±0.57 | 12.66±0.57 | 8.66±0.57 | 18.66±0.57 | 13.66±0.57 | 11.66±0.57 | 7.66±0.57 |
| C20 | - | - | - | 24.66±0.57 | - | - | - | 22.66±0.57 | - | - | - | 21.66±0.57 | - | - | - | 19.66±0.57 |
Note: C20 represents Chloramphenicol at 20 µg/ml, the diameter of the well (6 mm) was included in ZOI value. All the experiments were performed in triplicates and (Mean value±SD) were calculated.
Table 5: MIC (µg/ml) of the extracellular extract of EF6 against pathogenic bacterial strains
| Isolates | E. coli (MTCC-443) |
Klebsiella pneumoniae (MTCC-452) | Proteus vulgaris (MTCC-426) |
Pseudomonas aeruginosa (MTCC-424) |
Sphingomonas paucimobilis (MTCC-6363) | Bacillus subtilis (MTCC-441) | Bacillus pumilus (MTCC-432) |
Streptococcus pyogenes (MTCC-2327) |
Staphylococcus aureus (MTCC-3160) |
| EF6 (Fusarium sp.1) | 62.5 | 125 | 125 | 62.5 | 125 | 31.25 | 62.5 | 31.25 | 31.25 |
| MIC of chloramphenicol | 0.39 | 0.78 | 0.78 | 0.39 | 0.78 | 0.10 | 0.20 | 0.10 | 0.10 |
Note: All the experiments were performed in triplicates and average values were recorded

Fig. 5: MIC of the Extracellular extract of EF6 (Fusarium sp.1) by resazurin dye reduction method (column represents concentration: 1-positive control, 2-Negative control, 3-1000 µg/ml, 4-500 µg/ml, 5-250 µg/ml, 6-125 µg/ml, 7-62.5 µg/ml, 8-31.25 µg/ml, 9-15.625 µg/ml, 10-7.8125 µg/ml, 11-3.906 µg/ml, 12-1.953 µg/ml) and Row represents pathogenic strains, A=Klebsiella pneumoniae (MTCC-452), B= Pseudomonas aeruginosa (MTCC-424), C= Sphingomonas paucimobilis (MTCC-6363), D= E. coli (MTCC-443), E = Bacillus subtilis (MTCC-441), F=Streptococcus pyogens (MTCC-2327), G=Staphylococcus aureus (MTCC-3160), H=Bacillus pumilus (MTCC-432)

Fig. 6: Antifungal activity of EF6 i.e. Fusarium sp.1 against Aspergillus flavus MTCC-339
Table 6: Antifungal activity of the extracellular endophytic extract
| Isolate No. | The diameter of the zone of inhibition (mm) against different pathogenic fungi at different concentration (µg/ml) | ||
| Aspergillus flavus (MTCC-3396) | Aspergillus niger (MTCC-961) | ||
| 300 | 150 | 300 | |
| EF6 (Fusarium sp.1) | 11.66±0.57 | 7±0.5 | 12.66±0.57 |
| N20 | - | 17.66±0.57 | - |
Note: N20 represents Nystatin at 20 µg/ml, the diameter of the well (6 mm) was included in ZOI value. All the experiments were performed in triplicates and (Mean value±SD) were calculated
Table 7: MIC (µg/ml) of the extracellular fungal extracts against pathogenic fungal strains
| Isolate | Aspergillus flavus (MTCC-3396) | Aspergillus niger (MTCC-961) | Candida albicans (MTCC-854) |
| EF6 (Fusarium sp.1) | 125 | 125 | 31.25 |
| Nystatin | 3.13 | 3.13 | 0.39 |
Note: All the experiments were performed in triplicates and average values were recorded
DISCUSSION
Ethyl acetate extracts of bioactive endophytic fungal strains exhibit antibacterial activity as reported in previous studies by [27-31]. Endophytic fungal, EF6 (Fusarium sp.1) ethyl acetate extract was more active against, E. coli (MTCC-443) with the zone of inhibition of 20.66±0.57 mm, followed by Pseudomonas aeruginosa (MTCC-424), Klebsiella pneumoniae (MTCC-452), Sphingomonas paucimobilis (MTCC-6363), Proteus vulgaris (MTCC-426) with the zone of inhibition of 15.66±0.57 mm, 14.66±0.57 mm, 13.66±0.57 mm, 12.66±0.57 mm, respectively in case of Gram-negative bacteria. As reported by the following studies of [28-30, 32-34].
Several studies have been done to find MIC value of the extract, for example, Nigrospora sp. reduced the growth of dermatophytes with the MIC range of 50 and 100 μg/ml respectively [35]; Papulaspora immersa and Arthrinium state of Apiospora montagnei Sacc. were isolated from the roots of Smallanthus sonchifolius (yacón). The crude extracts from their cultures inhibited the growth of Staphylococcus aureus, Kocuria rhizophila, Pseudomonas aeruginosa and Escherichia coli. The more relevant results were observed in the ethyl acetate extract from P. immersa against P. aeruginosa with MIC (90 µg/ml) and ethyl acetate extract from Arthrinium state of A. montagnei Sacc. against P. aeruginosa with MIC (160 µg/ml). The two endophytic fungi isolated from yacón roots as well as their antimicrobial activity was detected in the crude extracts cultures were being reported for the first time [36]; Endophytic fungi isolated from Rafflesia cantleyi with anti-Candida activity having IC50 values of 3.5–8.2 μg/ml [37]. In the present study, the endophytic fungi isolated also have the MIC in the range of (31.25-125 μg/ml) for all bacterial and fungal strains used which is in agreement with the above study.
CONCLUSION
The endophytic fungus isolated from Tephrosia purpurea root was Fusarium sp.1 which has high antimicrobial activity. Hence, the endophytic fungus isolated from Tephrosia purpurea root might be a new antimicrobial source to combat with drug-resistant bacteria. Further studies on isolation of these antimicrobial compounds and identification of bioactive compounds can be a crucial approach to the search of novel natural products.
AUTHORS CONTRIBUTIONS
All the author have contributed equally
CONFLICT OF INTERESTS
Declared none
REFERENCES
Guo B, Wang Y, Sun X, Tang K. Bioactive natural products from endophytes: a review. Appl Biochem Microbiol 2008;44:136-42.
Strobel G, Daisy B. Bioprospecting for microbial endophytes and their natural products. Microbiol Mol Biol Rev 2003;67:491-502.
Berdy J. Bioactive microbial metabolites. A personal view. J Antibiot 2005;58:1-26.
Gunatilaka AA. Natural products from plant-associated microorganisms: distribution, structural diversity, bioactivity and implications of their occurrence. J Nat Products 2006;69:509-26.
Kusari S, Zuhlke S, Spiteller M. Effect of artificial reconstitution of the interaction between the plant Camptotheca acuminata and the fungal endophyte Fusarium solani on camptothecin biosynthesis. J Nat Prod 2011;74:764-75.
Yu H, Zhang L, Li L, Zheng C, Guo L, Li W, et al. Recent developments and future prospects of antimicrobial metabolites produced by endophytes. Microbiol Res 2010;165:437-49.
Strobel GA. Microbial gifts from rain forests. Can J Plant Pathol 2002a;24:14-20.
Strobel GA. Rainforest endophytes and bioactive products. Crit Rev Biotechnol 2002b;22:315-33.
Wiyakrutta S, Sriubolmas N, Panphut W, Thongon N, Danwiserkanjana K, Ruangrungsi N, et al. Endophytic fungi with antimicrobial, anti-cancer, anti-malarial activities isolated from Thai medicinal plants. World J Microbiol Biotechnol 2004;20:265-72.
Huang WY, Cai YZ, Xing J, Corke H, Sun M. Potential antioxidant resource: endophytic fungi isolated from traditional Chinese medicinal plants. Econ Bot 2007;61:14-30.
Kharwar RN, Gond SK, Kumar A, Kumar J, Mishra A. A comparative study of endophytic and epiphytic fungal association with the leaf of Eucalyptus citriodora Hook and their antimicrobial activity. World J Microbiol Biotechnol 2010;26:1941-8.
Fisher PJ, Petrini O. Tissue specificity by fungi endophytic in Ulex europaeus. Sydow 1987;40:46-50.
Suryanarayanan TS, Kumaresan V, Johnson JA. Foliar fungal endophytes from two species of the mangrove Rhizophora. Can J Microbiol 1998;44:1003-6.
Schulz B, Wanke U, Drager S, Aust HJ. Endophytes from herbaceous plants and shrubs: effectiveness of surface sterilization methods. Mycol Res 1993;97:1447-50.
Clinical Laboratory Standards Institute (CLSI), Performance standards for antimicrobial disk susceptibility tests, approved standard, M2-A8. 8th ed. CLSI, Wayne, PA, U. S. A; 2005.
NCCLS, National Committee for Clinical Laboratory Standards. Performance standards for antimicrobial susceptibility testing. In: Ninth Informational Supplement, Wayne, Pennsylvania M 100-S9; 1999.
Zhang Y, Mu J, Feng Y, Kang Y, Zhang J, Juan P, et al. Broad-spectrum antimicrobial epiphytic and endophytic fungi from marine organisms: isolation, bioassay, and taxonomy. Mar Drugs 2009;7:97-112.
Buatong J, Phongpaichit S, Rukachaisirikul V, Sakayaroj J. Antimicrobial activity of crude extracts from mangrove fungal endophytes. World J Microbiol Biotechnol 2011;27:3005-8.
Clinical and Laboratory Standards Institute (CLSI), Performance standards for antimicrobial disk susceptibility tests; approved standard. 10th Ed. M02-A10. CLSI, Wayne, PA. U. S. A; 2009.
Clinical and Laboratory Standards Institute (CLSI), Method for antifungal disk diffusion susceptibility testing of yeasts. Second edition. M44-A2. 2nd Ed. Wayne, PA, U. S. A; 2009.
Clinical Laboratory Standards Institute (CLSI), Method for antifungal disk diffusion susceptibility testing of filamentous fungi; proposed guideline. Document M51-P. CLSI, Wayne, PA, U. S. A; 2009.
Arivudainambi USE, Anand TD, Shanmugaiah V, Karunakaran C, Rajendran A. Novel bioactive metabolites producing endophytic fungus Colletotrichum gloeosporioides against multidrug-resistant Staphylococcus aureus. FEMS Immunol Medical Microbiol 2011;61:340-5.
Clinical Laboratory Standards Institute (CLSI), Development of in vitro susceptibility testing criteria and quality control parameters. 3rd ed. M23-A3. CLSI, Wayne, PA. U. S. A.; 2008.
Clinical Laboratory Standards Institute (CLSI), Performance standards for antimicrobial susceptibility testing: 21st informational supplement. M100-S21. CLSI, Wayne, PA, U. S. A.; 2011.
Gulnaz AR, Savitha G. Evaluation of antimicrobial activity of leaf and stem extracts of sidda medicinal plant Sida cordata. Int J Med Pharma Sci 2013;3:39-50.
Martin A, Camacho M, Portaels F, Carlos Palomino C. Resazurin microtiter assay plate testing of Mycobacterium tuberculosis susceptibilities to second-line drugs: rapid, simple, and inexpensive method. Antimicrob Agents Chemother 2003;47:3616-9.
Zou WX, Meng JC, Lu H, Chen GX, Shi GX, Zhang TY, et al. Metabolites of Colletotrichum gloeosporioides, an endophytic fungus in Artemisia mongolica. J Nat Prod 2000;63:1529-30.
Shu RG, Wang FW, Yang YM, Liu YX, Tan RX. Antibacterial and xanthine oxidase inhibitory cerebrosides from Fusarium sp., IFB-121 an endophytic fungus in Quercus variabillis. Lipids 2004;39:667-73.
Kamana Sahani, Deependra Thakur, KPJ Hemalatha, Arkajit Ganguly. Antibacterial activity of endophytes from selected medicinal plants. Int J Adv Res 2017;5:2076-86.
Chareprasert S, Piapukiew J, Thienhirun S, Anthony J, Whalley S, Sihanonth P. Endophytic fungi of teak leaves Tectona grandis L. and rain tree leaves Samanea saman merr. World J Microbiol Biotechnol 2006;22:481-6.
Wu JG, Peng W, Zeng PY, Wu YB, Yi J, Wu JZ. Antimicrobial activity and cytotoxicity of endophytes from Scapania verrucosa heeg. Genetics Mol Res 2013;12:916-24.
Raviraja NS, Maria GL, Sridhar KR. Antimicrobial evaluation of endophytic fungi inhabiting medicinal plants of the Western Ghats of India. Engin Life Sci 2006;6:515-20.
Wang FW, Jiao RH, Cheng AB, Tan SH, Song YC. Antimicrobial potentials of endophytic fungi in Quercus variabillis, brefeldin a obtained from Cladosporium sp. World J Microbiol Biotechnol 2007:23:79-83.
Xu L, Zhou L, Zhao J, Li J, Li X, Wang J. Fungal endophytes from Dioscorea zingiberensis rhizomes and their antibacterial activity. Lett Appl Microbiol 2007;46:68-72.
Verma S, Singh SP. Current and future status of herbal medicines. Veterin World 2008;1:347-50.
Ramos HP, Braun GH, Pupo MT, Said S. Antimicrobial activity of endophytic fungi Arthinium state of Apiospora montagnei Sacc. and Papulospora immerse. Brazilian Arch Biol Technol 2010;53:629-32.
Refaei J, Jones EBG, Sakayaroj J, Santhanam J. Endophytic fungi from Rafflesia cantleyi: species diversity and antimicrobial activity. Mycosph 2011;2:429-47.